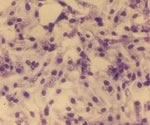

анализ на хламидиоз
Вопросы и ответы по: анализ на хламидиоз
Для контроля излечиваемости сдавал анализы на хламидиоз, ПЦР в реальном времени дал результат "не обнаружено", тогда как посев (культуральный метод) показал результат "выделено". Как это трактовать?
Антитела IgG к Chl.trachomatis ОПс.=1,007 - положительный; Ед. измерения оптич.плотность ; Норма: ОПсыв.< ОПкрит.-отрицательный;ОПсыв.> или = ОПкрит. - положительный.
Можно ли с уверенностью говорить о наличии хламидии и как еще можно перепровериться? Из симптомов-частая температура 37-37,5, слабость, отсутствие эрекции, выделений нет, насморк,першение горла
Хламидиоз IgG Отрицательно
Хламидиоз IgM Отрицательно
Вирус Герпеса IgG Положительный
Вирус Герпеса IgM Отрицательный
Микоплазмоз IgG сомнительно
Микоплазмоз IgM отрицательный
Уреаплазмоз IgG отрицательный
Уреаплазмоз IgM отрицательный
Трихомониаз IgG отрицательный
ТрихомониазIgM отрицательный
CMV IgG(Цитомегаловирус)500.0 положительно <0.5 U/ml
CMV IgM(Цитомегаловирус)0.200 отрицательно <0.8 COI
Toxo IgM (токсоплазмоз)0.222 отрицательно <0.8 COI
Toxo IgG (токсоплазмоз)0.130 отрицательно < 1 IU/ml
Rubella IgG(Краснуха) 188,600 положительно < 10 IU/ml
Rubella IgG(Краснуха) 0,461 отрицательно <0.8 COI
Популярные статьи на тему: анализ на хламидиоз

Урогенитальный хламидиоз нередко протекает бессимптомно, но его осложнения грозят серьезными проблемами со здоровьем. Узнайте, что является основанием для предположения о наличии хламидийной инфекции, как лечиться и не допустить повторного заражения.

Урогенитальный хламидиоз – высококонтагиозное инфекционное заболевание, передаваемое половым путем.

Анализ мазка, полученного во время гинекологического обследования, дает много информации о состоянии здоровья женщины. По результатам можно судить не только о составе микрофлоры и наличии воспалительных процессов, но и о вероятности ракового заболевания.

Хламидии широко распространены в природе. Они выявлены не только у человека, но и более, чем у 200 видов млекопитающих и птиц. Виды C. trachomatis и C. pneumoniae первично патогенны для человека, a C. psittaci и C. pecorum —.

В этиологическом спектре воспалительных заболеваний органов малого таза преобладают хламидии, моликуты, вирусы, все чаще встречающиеся во множественных и разнообразных ассоциациях.

Бактериальный вагиноз: нехарактерные влагалищные выделения, зуд и жжение, расстройства мочеиспускания, боль в области влагалища или промежности, - Вас беспокоит что-либо из этих симптомов? Узнайте как правильно лечить заболевание и не допустить осложнений

Папилломавирусная инфекция относится к заболеваниям, передаваемым половым путем, и вызывается Human papilloma virus – ВПЧ.

Бактериальные инфекции влагалища являются наиболее распространенными заболеваниями, встречающимися в гинекологической практике.

Дерматокосметология как направление медицинской деятельности существует с незапамятных времен, поскольку ее предмет отражает постоянное и естественное стремление человека к красоте и здоровью тела.
Новости на тему: анализ на хламидиоз

Хламидиоз относится к самым распространенным инфекциям, передающимся половым путем. Диагностика этого заболевания в отличие от других венерических болезней является трудной задачей – а в Англии изобрели анализатор, выявляющий хламидии за полчаса.

Хламидиоз является очень распространенным заболеванием, передающимся половым путем. Теперь диагностировать эту болезнь можно будет прямо во время посещения врача: метод экспресс-анализа позволяет получить точный результат за 20 минут.

Очевидно, руководители медицинского ведомства Австралии являются людьми, обладающими здравым смыслом и мыслящими реальными категориями. Чтобы остановить в стране рост заболеваемости хламидиозом и другими половыми инфекциями, любой молодой человек или девушка (не обязательно больные ЗППП), которые придут в больницу и согласятся сдать анализ на наличие хламидий, немедленно получат сумму в местной валюте, эквивалентную 10 долларам США. Можно ожидать, что с помощью такой меры кривая заболеваемости хламидиозом резко пойдет вниз. Материальный стимул гораздо эффективнее всех пропагандистских лекций и плакатов о вреде случайных связей и незащищенного секса.
Новый анализ мочи позволит врачам диагностировать у мужчин инфицирование хламидиями в течение часа. Это увеличит шансы успешного лечения данного заболевания и предотвратит дальнейшее его распространение.

Смартфоны давно превратились из коммуникационных устройств в гаджеты, позволяющие решать самые разные задачи – от игр онлайн до виртуальных экскурсий в музеи. Теперь ученые из США с помощью смартфонов могут еще и диагностировать хламидиоз.

Молодые люди, живущие половой жизнью, должны ежегодно сдавать анализы на наличие инфекции под названием хламидия. Также такой анализ рекомендуется проводить каждый раз при смене партнера, сообщают ученые

У девушек в подростковом возрасте отмечен высокий уровень заболеваемости инфекциями, передающимися половым путем (ППИ). Согласно данным анализа заболеваемости ППИ девушек в возрасте от 14 до 19 лет за 2003-2004 гг., у 25,7 % (что составило 3,2 млн) молодых девушек обнаружено хотя бы 1 з инфекций, передающихся половым путем

Новый отчет властей США показал, что у каждой четвертой школьницы в стране в возрасте от 13 до 19 лет имеется заболевание, передающееся половым путем (ЗППП). Многие из них заражаются уже при первом своем половом контакте.

Согласно результатам нового исследования Центра по контролю и предотвращению заболеваний, каждая четвертая молодая женщин в США (более 26%) в возрасте от 14 до 19 лет является носителем по крайней мере одного инфекционного заболевания, передающегося половым путем




